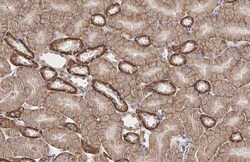
Invitrogen GPX8 Recombinant Rabbit Monoclonal Antibody (HL2635) 100 &mu;L;

missing translation for 'onlineSavingsMsg'
Learn More
Learn More
Invitrogen™ GPX8 Recombinant Rabbit Monoclonal Antibody (HL2635)


Rabbit Recombinant Monoclonal Antibody
Brand: Invitrogen™ MA556730
This item is not returnable.
View return policy
Description
GPX8 Recombinant Monoclonal Antibody for Western Blot, IHC (P)
GPX8 (Probable glutathione peroxidase 8) is also named as GSHPx-8 and belongs to the glutathione peroxidase family. Glutathione peroxidase (GPx) reduces hydroperoxides, including hydrogen peroxides, in the presence of reduced glutathione as a means of protecting organisms from oxidative damage. Several GPx isozymes have been identified in animal cells and these have been classified into different groups according to their cellular location and substrate specificity. In humans, eight types of GPx have been identified from GPx1 to GPx8. The full length GPX8 has 209 amino acids and the molecular weight is 24 kDa.
Specifications
| GPX8 | |
| Recombinant Monoclonal | |
| 1 mg/mL | |
| PBS with no preservative | |
| Q8TED1, Q9D7B7 | |
| GPX8 | |
| Recombinant fragment of human GPX8. | |
| 100 μL | |
| Primary | |
| Human, Mouse, Rat, Canine | |
| Antibody | |
| IgG |
| Immunohistochemistry (Paraffin), Western Blot | |
| HL2635 | |
| Unconjugated | |
| GPX8 | |
| 2310016C16Rik; AU017063; EPLA847; glutathione peroxidase 8; glutathione peroxidase 8 (putative); GPX8; GPx-8; GSHPx-8; probable glutathione peroxidase 8; RGD1307506; UNQ847; UNQ847/PRO1785 | |
| Rabbit | |
| Protein A | |
| RUO | |
| 294744, 478059, 493869, 69590 | |
| -20°C, Avoid Freeze/Thaw Cycles | |
| Liquid |
Product Content Correction
Your input is important to us. Please complete this form to provide feedback related to the content on this product.
Product Title
Spot an opportunity for improvement?Share a Content Correction